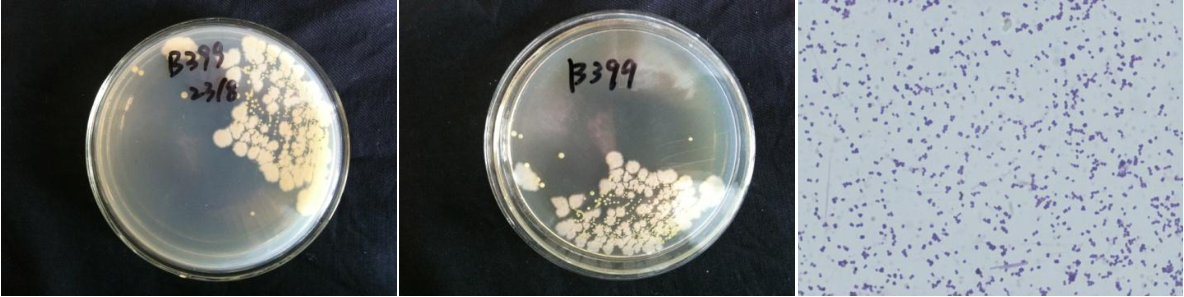

Loading...
| StrainNO | B399 |
| Classification | Bacillus |
| 16s rDNA sequence | AGGCGGCTGGCTCCAAAAAGGTTACCCCACCGACTTCGGGTGTTACAAACTCTCGTGGTGTGACGGGCGGTGTGTACAAGGCCCG GGAACGTATTCACCGCGGCATGCTGATCCGCGATTACTAGCGATTCCAGCTTCATGTAGGCGAGTTGCAGCCTACAATCCGAACT GAGAACGGTTTTATGAGATTAGCTCCACCTCGCGGTCTTGCAGCTCTTTGTACCGTCCATTGTAGCACGTGTGTAGCCCAGGTCA TAAGGGGCATGATGATTTGACGTCATCCCCACCTTCCTCCGGTTTGTCACCGGCAGTCACCTTAGAGTGCCCAACTTAATGATGG CAACTAAAAACAAGGGGTGGCGCTCGTTGCGGGACTTAACCCAACATCTCACGACACGAGCTGACGACAACCATGCACCACCTGT CACTCTGCTCCCGAAGGAGAAGCCCTATCTCTAGGGTTTTCAGAGGATGTCAAGACCTGGTAAGGTTCTTCGCGTTGCTTCGAAT TAAACCACATGCTCCACCGCTTGTGCGGGCCCCYGTCAATTCCTTTGAGTTTCAGCCTTGCGGCCGTACTCCCCAGGCGGAGTGC TTAATGCGTTAACTTCAGCACTAAAGGGCGGAAACCCTCTAACACTTAGCACTCATCGTTTACGGCGTGGACTACCAGGGTATCT AATCCTGTTTGCTCCCCACGCTTTCGCGCCTCAGTGTCAGTTACAGACCAGAAAGTCGCCTTCGCCACTGGTGTTCCTCCATATC TCTACGCATTTCACCGCTACACATGGAATTCCACTTTCCTCTTCTGCACTCAAGTCTCCCAGTTTCCAATGACCCTCCACGGTTG AGCCGTGGGCTTTCACATCAGACTTAAGAAACCACCTGCGCGCGCTTTACGCCCAATAATTCCGGATAACGCTTGCCACCTACGT ATTACCGCGGCTGCTGGCACGTAGTTAGCCGTGGCTTTCTGGTTAGGTACCGTCAAGGTGCCAGCTTATTCAACTAGCACTTGTTCTTCCCTAACAACAGAGTTTTACGACCCGAAAGCCTTCATCACTCACGCGGCGTTGCTCCGTCAGACTTTCGTCCATTGCGGAAG ATTCCCTACTGCTGCCTCCCGTAGGAGTCTGGGCCGTGTCTCAGTCCCAGTGTGGCCGATCACCCTCTCAGGTCGGCTACGCATC GTTGCCTTGGTGAGCCGTTACCTCACCAACTAGCTAATGCGACGCGGGTCCATCCATAAGTGACAGCCGAAGCCGCCTTTCAATT TCGAACCATGCGGTTCAAAATATTATCCGGTATTAGCCCCGGTTTCCCGGAGTTATCCCAGTCTTATGGGCAGGTTACCCACGTG TTACTCACCCGTCCGCCGCTAACTTCATAAGAGCAAGCTCTTAATCCATTCGCTCGACTTGCATGTA |
| Strain Morphology Photos | |
| Morphological Description | round;light yellow;steamed bun shaped;edge neatly;bright;sticky;spherical;no spore |